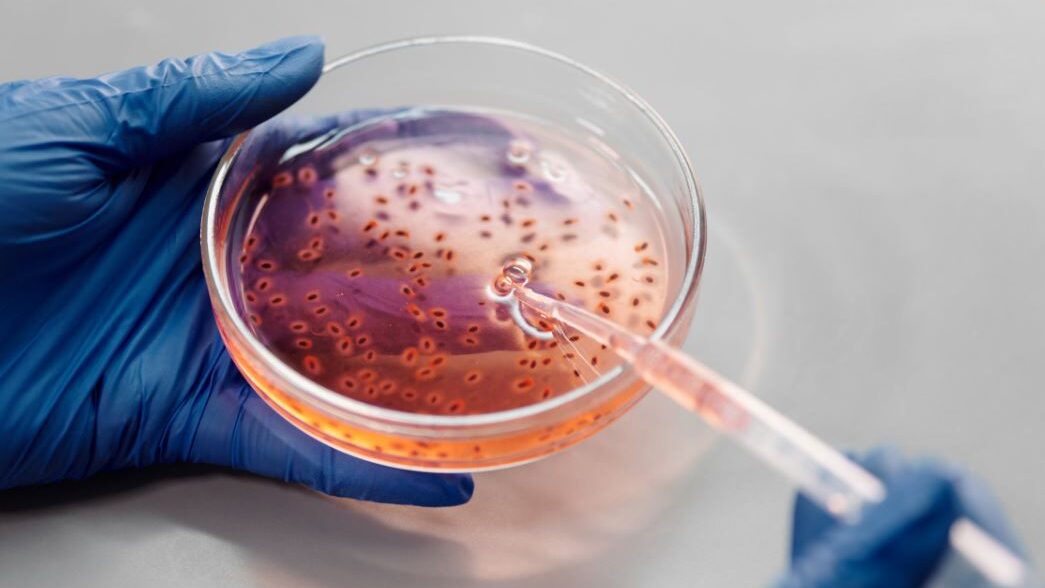
Manos con guantes sosteniendo una placa de Petri con líquido y una pipeta.

El deporte, los atletas y las personas transgénero
Desde tiempos inmemoriales, los deportes han sido una parte importante de la cultura. Muchas personas hacen deporte como un pasatiempo, mientras que otras lo hacen de manera profesional. En la mayoría de las actividades deportivas, existe la competencia. Y las competencias tienen primeros, segundos y terceros puestos.
Es sobre todo por el tema de la competencia que, cuando las personas trans comenzaron a reclamar derechos humanos básicos, la discusión sobre su participación en los deportes se volvió un tema controvertido. Sin embargo, hay que entender que si los deportes buscan promover la disciplina y el espíritu deportivo, si su objetivo es entretener y mejorar las vidas de las personas, algunas tradiciones no van de la mano con la lucha por la inclusión.
En esta página
Las diferencias de género en los deportes
Los fundamentos del deporte son conocidos, por lo que vamos a centrarnos en algunas distinciones. Tradicionalmente, los deportes competitivos y los acontecimientos deportivos han impuesto una división: la separación de las competencia sobre la base del género.
Naturalmente, la mayoría de los hombres son físicamente más fuertes que las mujeres. Entonces, para que las competencias sean más equitativas, se los separa. Por eso, existen, por ejemplo:
- la NBA (para hombres) y la WNBA (para mujeres)
- la NFL (para hombres) y la WNFL (para mujeres)
- y otras ligas diferenciadas por género.

Cuando las personas transgénero, sobre todo las mujeres trans, comenzaron a reclamar derechos humanos básicos, los deportes se vieron afectados. Muchas personas no están de acuerdo con que las mujeres transgénero compitan en deportes femeninos.
Estas personas creen que las mujeres cis están en desventaja, ya que asumen que las mujeres trans son naturalmente más fuertes y rápidas. Si bien el argumento podría ser válido, sentó las bases para que se excluyera a las mujeres trans de las competencias deportivas nacionales.
Personas transgénero, deportes y deportistas trans
El debate sobre la inclusión de las mujeres trans en los deportes femeninos deriva en el asunto de las hormonas y la fuerza física, en el que se ha arribado a algunos compromisos.
Para que la competencia sea más equitativa, algunos eventos deportivos verifican los niveles hormonales de las mujeres transgénero antes de comenzar. Si están en el rango de lo femenino, se les permite competir contra las mujeres cis.

Sin embargo, no todos los organizadores están abiertos a esta práctica. Además, a la mayoría de los seguidores no les parece justo para las mujeres cis.
En 2021, todavía no se han establecido estándares que les permitan a las mujeres trans participar de eventos deportivos femeninos. Tampoco se ha avanzado en la creación de competencias exclusivas para personas trans. Sin embargo, esto no significa que no existan deportistas transgénero.
2021: novedades sobre las personas trans en los deportes
En 2021, tuvimos un resquicio de esperanza cuando el presidente Joe Biden asumió su cargo, ya que dictó una orden ejecutiva para incluir a todas las atletas transgénero en eventos deportivos.
Dicha orden ejecutiva tiene por objeto prevenir y combatir la discriminación por motivos de identidad de género u orientación sexual, y Biden la firmó el día de la investidura presidencial. Entre otras cosas, establece que las instituciones educativas que reciben financiamiento del Gobierno deben permitirles a las personas que se identifican como mujeres formar parte de los equipos deportivos femeninos de las escuelas.
Sin embargo, algunas mujeres de alto perfil no recibieron bien esta noticia. Se trata de algunas estrellas del deporte femenino muy conocidas, incluida Martina Navrátilová, que es una múltiple campeona olímpica y una leyenda del tenis.
El enfoque científico para la inclusión de las mujeres trans en los deportes femeninos
De todas maneras, no están protestando contra la orden ejecutiva sin fundamentos. Nancy Hogshead-Makar, abogada y una de las líderes del Women’s Sports Policy Working Group (grupo de trabajo sobre políticas en deportes femeninos) sostiene:
Apoyamos plenamente la orden ejecutiva de Biden para ponerle fin a la discriminación contra las personas LGBT en todos los ámbitos de la sociedad, incluidos el empleo, el acceso a la bancarización, el derecho de familia y los espacios públicos. Sin embargo, los deportes competitivos tienen similitudes con el embarazo y los estudios médicos. Son áreas que requieren un enfoque científico para la inclusión de las personas transgénero. Nuestro objetivo ha sido proteger las categorías competitivas de niñas y mujeres mientras diseñamos un lugar para las atletas trans en el deporte siempre que sea posible.
posición del Comité Olímpico Internacional sobre los atletas trans
En la actualidad, la política del Comité Olímpico Internacional, definida en 2015, establece que las mujeres trans pueden competir en deportes femeninos si llevan 12 meses suprimiendo la testosterona mediante el uso de medicamentos.
Hoy en día, se está pensando en cambiar esta política y hacer que todas las atletas cumplan con cierto nivel de testosterona.
Deportes, escuela y atletas trans
Se habla mucho sobre si las adolescentes trans pueden o no participar de los deportes femeninos en la secundaria.
Hay personas que creen que las niñas trans tienen una ventaja sobre las cis. Sin embargo, un entrenador de escuela secundaria retirado sostiene lo contrario.
Estas con las palabras de Larry Strauss, un profesor de inglés y entrenador de baloncesto retirado del sur de Los Ángeles:
En la vida real, la participación de las niñas trans en los deportes no genera controversia. Tardamos mucho en dejar de excluir a los atletas de color de los deportes escolares y universitarios. ¿Cuánto tiempo más van a tratar de excluir a los atletas trans?
Qué significa la presidencia de Joe Biden para los atletas trans
Aunque la meta de inclusión de Joe Biden es noble, hay ciertos protocolos que deben observarse antes de que se firme la ley. Los deportes son altamente competitivos y quienes ganan deben hacerlo en función de:
- imparcialidad
- mérito
- y trabajo duro

Actualmente, hay mucha confusión alrededor de la orden ejecutiva. Hogshead-Makar añadió:
Si bien los detalles de la orden ejecutiva del presidente Biden siguen siendo confusos, pedirles —o, en realidad, exigirles— a las mujeres que renuncien al derecho por que el lucharon de competir y ser reconocidas en el deporte de élite, con igualdad de oportunidades, becas, premios, publicidad, honor y respeto, no ayuda a la causa de la inclusión de las personas transgénero.
También sostuvo:
Genera un resentimiento justificado y complica la lucha por la igualdad en toda la sociedad. Y cualquiera de las dos posiciones extremas, inclusión total o exclusión total en el deporte, le hará la vida mucho más difícil a las personas trans. Tenemos que hacer que el deporte sea un lugar acogedor para todos.
Atletas transgénero famosos
En medio de toda esta confusión, los atletas trans existen. Algunos incluso son deportistas olímpicos.
Caitlyn Jenner
Es una de las atletas trans más conocidas de todos los tiempos, si no la más. Sin embargo, las medallas de oro olímpicas las ganó antes de transicionar. Obtuvo su primer éxito en 1974, en un evento de decatlón masculino. También obtuvo el primer lugar en los Juegos Panamericanos de 1975 y en los Juegos Olímpicos de 1976.
Su fama como deportistas le ganó el puesto de portavoz de la marca de cereales Wheaties en los años setenta. En la misma época, apareció en varios programas de televisión y películas.

Hoy en día, es más famosa por haber salido del clóset como mujer transgénero. Lo hizo mientras trabajaba en el programa de televisión Los Kardashian, en el que era conocida como el patriarca de la familia.
Hubo muchas reacciones negativas, pero fue un paso importantísimo para la comunidad trans. Debido a la enorme audiencia del reality show, su historia llegó a una cantidad impresionante de personas. Su coraje hizo que muchas personas abrieran los ojos y aprendiera acerca de las persona transgénero.
Sigue a Caitlyn Jenner: Facebook | Instagram | Youtube | IMDb
Chris Mosier
Mosier comenzó su carrera como atleta antes de transicionar. En 2015, formó parte del equipo masculino de duatlón sprint de Estados Unidos para el Campeonato Mundial de 2016. Se hizo conocido por ser el primer miembro abiertamente transgénero de un equipo nacional de Estados Unidos.

Pero Chris Mosier no solo ha trabajado en su propia carrera. También es el fundador de transathlete.com, un sitio web que funciona como recurso para que los atletas trans, los entrenadores, los estudiantes y los administradores se enteren de los avances en la inclusión de las personas trans en el mundo del deporte.
Además, está trabajando con diferentes organizaciones deportivas para fortalecer la inclusión de los atletas trans en el mundo del deporte. En 2020, compitió en las pruebas por equipos olímpicos de Estados Unidos para los 50 km de marcha atlética, pero no consiguió la clasificación porque se lesionó durante la carrera.
Sigue a Chris Mosier: Facebook | Instagram | Threads | Youtube | TikTok | Sitio Oficial
Lia Thomas
Probablemente sea una de las atletas transgénero más controvertidas hoy en día. Lia Catherine Thomas, la primera atleta abiertamente trans en ganar un campeonato nacional de la NCAA, generó muchos debates acerca de la inclusión de las mujeres trans en los deportes.

Thomas ganó la carrera femenina de 500 yardas de estilo libre, pero mucha gente cuestionó esa victoria. Fox News y varios medios religiosos cubrieron los pedidos anónimos de padres de miembros del equipo de natación de la Universidad de Pensilvania, que le exigían a la institución que declarara que Lia no podía competir.
Brooke Forde, una medallista olímpica, dijo al respecto:
Creo que tratar a las personas con respeto y dignidad es más importante que cualquier trofeo o récord, por lo que no tengo problema de competir contra Lia en las competencias de la NCAA este año.
Otra nadadora, la medallista olímpica Erica Sullivan, apoyó a Thomas en un artículo de opinión para Newsweek, en el que decía:
Como todos los que compiten en este deporte, Lia ha entrenado con esmero para llegar a donde está y ha seguido todas las reglas y las normas que le han presentado… No siempre gana. Y, cuando lo hace, se merece, como cualquier otra persona, que se la felicite por su éxito, alcanzado con trabajo duro. No se merece que la etiqueten de tramposa simplemente por su identidad.
Sigue a Lia Thomas: Instagram
Renée Richards
Richards es una oftalmóloga y exjugadora de tenis. A diferencia de Jenner, ganó varias competencias jugando contra mujeres cis. Tuvo una carrera exitosa en el circuito deportivo profesional durante la década de los setenta.
Se la conoce por haber peleado para competir en el Abierto de Estados Unidos, en 1976, después de haberse sometido a una cirugía de reasignación de género.

Richard Carlson, un presentador de televisión local, develó que era una mujer trans en 1976. A causa de esto,
- la Asociación de Tenis de los Estados Unidos (USTA)
- el Comité Olímpico Estadounidense (USOC)
- y la Asociación de Tenis Femenino (WTA)
comenzaron a obligar a las competidoras a someterse a una verificación de género a través de pruebas cromosómicas.
Richards se negó a realizarse la prueba y no se le permitió competir en el Abierto de Estados Unidos ni en Wimbledon en 1976. Posteriormente, demandó a la USTA por discriminación por género en violación de la Ley de derechos humanos de la ciudad de Nueva York. Debido a eso, pudo jugar en el Abierto de Estados Unidos de 1977.
El futuro de los atletas transgénero
Algunas personas creen que debería haber categorías exclusivas para las personas trans. Sin embargo, esto va en contra de la lucha por la inclusión. Se están dando muchos debates, porque tanto quienes están en contra como quienes están a favor tienen muy buenos argumentos.
Todavía hay un largo camino por recorrer en término de inclusión de atletas trans en los deportes. Si quieres debatir el respecto con tus amigos a los que les interesa el mundo del atletismo, puedes compartirles este artículo.